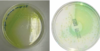

(exam 2) ch 21 Microbial diseases of the skin and eyes Flashcards
(103 cards)
what are the two primary parts?
1) Epidermis 2) Dermis
what is the epidermis?
Outermost portion contains rows of dead cells; thin outer portion of skin; composed of layers of epithelial cells
keratin?
waterproofing protein coating outer layer of epidermis
what is the dermis?
inner, thick portion of skin; composed mainly of connective tissue
what are three passageways for microbes?
1) hair follicles 2) sweat gland ducts 3) oil gland ducts
what is sebum?
secreted by oil glands contains fatty acids that inhibit pathogens (but, Some microbes can use sebum for growth)
what are mucous membranes (mucosa) ?
Sheets of tightly packed epithelial cells attached to an extracellular matrix (Cells secrete mucus and some cells have cilia) - often folded to maximize surface area
what is exanthem?
skin rash arising from a disease
what is enanthem?
rash on mucous membranes arising from a disease
what are vesicles?
small, fluid-filled lesions; less than 1 cm

what is bullae?
vesicles larger than 1 cm in diameter

what are macules?
flat, reddened lesions; less than 1 cm

what are papules?
raised lesions
what are pustules?
raised lesions with pus

what two genera typically cause bacterial skin diseases?
Staphylococcus and Streptococcus frequently cause skin infections
what is Staphylococci?
spherical gram-positive bacteria; form irregular clusters

how are Staphylococcal skin infections clinically divided into two groups?
dependent on coagulase production
what is coagulase?
enzyme that clots fibrin in the blood
what is Staphylococcus epidermidis?
~90% of normal skin microbiota (Opportunistic pathogen); Healthcare-associated pathogen; Produces biofilm on catheters; Coagulase-negative
what is Staphylococcus aureus?
Carried in the nasal passages; Golden-yellow colonies (protects them from sunlight); Most pathogenic strains are coagulase-positive and these strains may also produce additional toxins; MRSA strains are antibiotic-resistant.
Staphylococcus aureus is often transported via Autoinoculation which means?
Infection caused by the spread of bacteria from one part of the body to another
what are two main types of Staphylococcus aureus infections?
- Hair follicle infections
- Impetigo
what is Folliculitis?
(Staphylococcus aureus- hair follicle infection) infections of hair follicles (often pimples)
what is a sty?
(Staphylococcus aureus – hair follicle infections) folliculitis of an eyelash